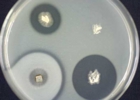

日時: 2014年11月1日(土) 10:00-16:00、11月8日(土) 10:00-16:00
場所: 茨城大学教育学部
共催: 茨城大学
講師: 小野 義隆 (茨城大学教育学部)
講義:真菌と微生物、現生生物にとっての閉鎖系である地球での物質の循環、物質循環過程での土壌の形成と植物の生育、土壌形成に関わる真菌。
実験・観察:リター分解菌(未同定)の炭水化物とタンパク質の分解、身近な真菌(アオカビ、コウジカビ、クラドスポリウム、パンコウボ)と細菌(ナットウキン)の炭水化物とタンパク質の分解、スライドカルチャーによる身近な真菌の菌糸成長と胞子形成の観察、ササクレヒトヨタケの培養観察。
感想など:きのこ栽培をしてきたが真菌の正体をみたのは初めて、カビときのこは同じ生き物なのがよくわかった、リター分解菌と家に生えるカビとは関係していることがよくわかった、実験や顕微鏡観察は初めてであったがカビの美しさがよくわかった、などの感想をいただきました。また、受講者数は少なかったのですが、ほとんどが「菌類の生物学」を購入し、さらに学習を深めるとの意欲を示していました。この講座は、中学校3年理科「生物と環境ー自然界のつり合い」での教材開発に資することを目指し、学校教員の参加を期待してましたが、実施日程等の都合で、現職教員の参加はありませんでした。
担当 小野 義隆
![]() |
![]()
|
![]() |
![]()
|
|